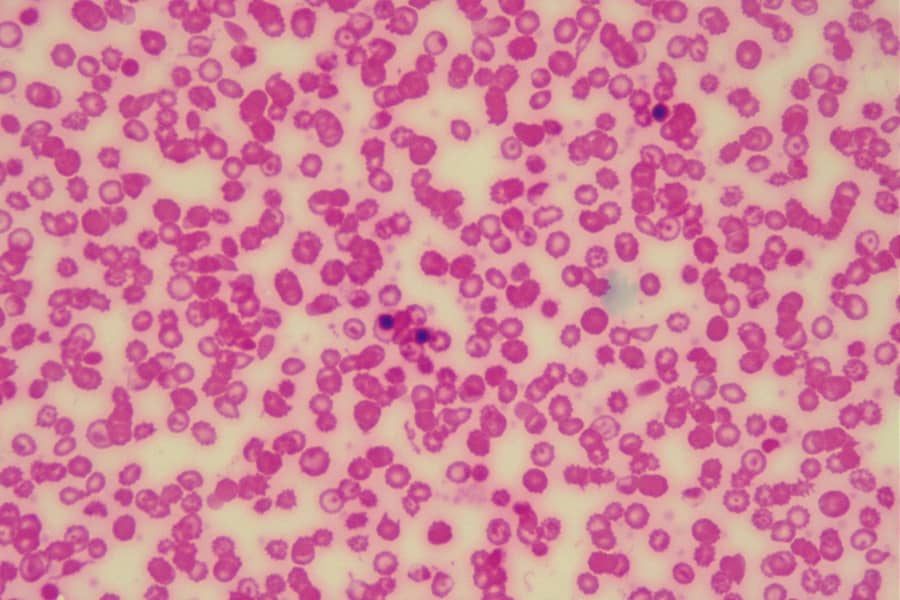

globus medical stock tsx
Within the last quarter Globus Medical NYSEGMED has observed the following analyst ratings. Is a leading musculoskeletal implant manufacturer and is based in Audubon Pennsylvania.

Globus Medical Continuing To Harness Innovation To Drive Impressive Growth Nyse Gmed Seeking Alpha
Class A GMEDUS plus the latest news recent trades charting insider activity and analyst ratings.

. These 4 analysts have an average price target of 685 versus the. The low in the last 52 weeks of Globus Medical stock was 5264. Stock was originally listed at a price of 1350 in Aug 3 2012.
Looking back over the last four weeks Globus Medical. The company was founded in 2003 by an experienced team of professionals. Real-time Price Updates for Globus Medical Inc GMED-N along with buy or sell indicators analysis charts historical performance news and more.
Analysts have provided the following ratings for Globus Medical NYSEGMED within the last quarter. It is focused on implants that promote healing in patients with musculoskeletal disorders including the use of a robotic. Globus Medical Inc is a medical device company that develops and provides healthcare products and solutions to hospitals physicians and surgical centers.
A high-level overview of Globus Medical Inc. The average Globus Medical stock price prediction forecasts a potential upside of 2456 from the current. According to the issued ratings of 9 analysts in the last year the consensus rating for Globus Medical stock is Moderate Buy based on the current 1 hold rating and 8 buy ratings.
The Globus Medical Inc stock price gained 178 on the last trading day Friday 21st Oct 2022 rising from 6227 to 6338During the last trading day the stock fluctuated. The stock has a market capitalization of 623 billion a PE ratio of 4200 a price-to. 1 hour agoGlobus Medical Trading Up 05.
Globus is inspired by the needs of patients and the surgeons. Shares of NYSE GMED opened at 6258 on Monday. Get the latest stock price for Globus Medical Inc.
Their GMED share price forecasts range from 6600 to 10000. Get the latest Globus Medical Inc GMED real-time quote historical performance charts and other financial information to help you make more informed trading and investment decisions. We value your privacy.
Globus Medical traded at 5829 this Friday September 23rd increasing 055 or 095 percent since the previous trading session. Stay up to date on the latest stock price chart news analysis fundamentals trading and investment tools. Is a medical device company.
11 brokers have issued 1 year target prices for Globus Medicals shares. We are seeking talented individuals to develop manufacture and distribute state-of-the-art musculoskeletal device products. Real-time trade and investing ideas on Globus Medical Inc - Ordinary Shares - Class A GMED from the largest community of traders and investors.
Globus Medical Inc. These 5 analysts have an average price target of 698 versus the current price. If you had invested in Globus Medical stock at 1350 your return over the last 10 years would.
On average they predict the.

Globus Medical Inc Gmed Stock 10 Year History
Gmed Globus Medical Inc Stock Overview U S Nyse Barron S

Globus Medical Mission Benefits And Work Culture Indeed Com

Gmed Stock Forecast Price News Globus Medical
Globus Medical Nyse Gmed Now Covered By Analysts At Barclays Marketbeat

Globus Medical Gmed Stock Price News Info The Motley Fool

Globus Medical Culture Comparably
Globus Medical Inc Nyse Gmed Receives Consensus Recommendation Of Moderate Buy From Analysts Marketbeat

8 Surgical Robotics Stocks Updated 2022

Gmed Globus Medical Inc Stock Overview U S Nyse Barron S

Gmed Stock Price And Chart Nyse Gmed Tradingview

Is Globus Medical Inc Nyse Gmed Potentially Undervalued Simply Wall St News

Gmed Stock Price And Chart Nyse Gmed Tradingview

About Us And Our Medical Devices Globus Medical

Globus Medical Inc Gmed Stock Price Quote News Stock Analysis

Nick Winfrey Spine Territory Manager Globus Medical Linkedin

Globus Medical Inc Stock Quote Stock Price For Gmed Financialcontent Business Page

